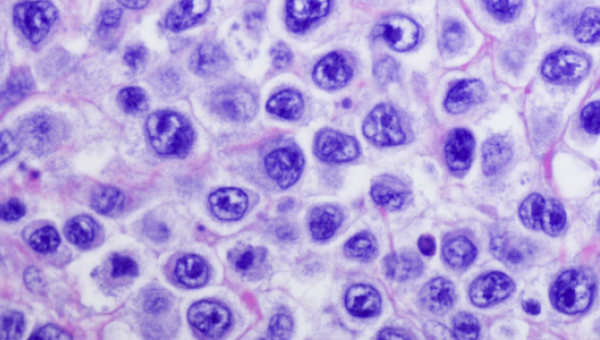

Como usuario registrado en aulario.roche.es puedes:
Recibir sugerencias personalizadas de interés
Consultar el histórico de visualizaciones o cursos
Acceder a la totalidad de los contenidos de formación
Obtener certificados de los cursos